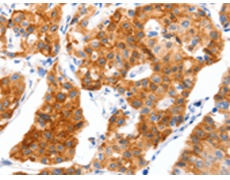
一抗

中文名稱:兔抗SLC2A4多克隆抗體
英文名稱: Anti-SLC2A4 rabbit polyclonal antibody
別 名: GLUT4
相關(guān)類別: 一抗
儲(chǔ) 存: 冷凍(-20℃)
宿 主: Rabbit
抗 原: SLC2A4
反應(yīng)種屬: Human, Mouse, Rat
標(biāo)記物: Unconjugate
克隆類型: rabbit polyclonal
技術(shù)規(guī)格
|
Background: |
This gene is a member of the solute carrier family 2 (facilitated glucose transporter) family and encodes a protein that functions as an insulin-regulated facilitative glucose transporter. In the absence of insulin, this integral membrane protein is sequestered within the cells of muscle and adipose tissue. Within minutes of insulin stimulation, the protein moves to the cell surface and begins to transport glucose across the cell membrane. Mutations in this gene have been associated with noninsulin-dependent diabetes mellitus (NIDDM). |
|
Applications: |
ELISA, IHC |
|
Name of antibody: |
SLC2A4 |
|
Immunogen: |
Synthetic peptide of human SLC2A4 |
|
Full name: |
solute carrier family 2 (facilitated glucose transporter), member 4 |
|
Synonyms: |
GLUT4 |
|
SwissProt: |
P14672 |
|
ELISA Recommended dilution: |
2000-5000 |
|
IHC positive control: |
Human lung cancer and Human colon cancer |
|
IHC Recommend dilution: |
50-200 |

 購物車
購物車 幫助
幫助
 021-54845833/15800441009
021-54845833/15800441009